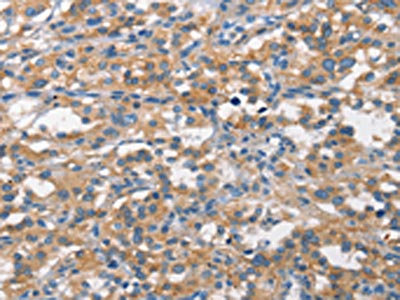

ALCAM Antibody
-
中文名稱:ALCAM兔多克隆抗體
-
貨號:CSB-PA104246
-
規格:¥1100
-
圖片:
-
The image on the left is immunohistochemistry of paraffin-embedded Human thyroid cancer tissue using CSB-PA104246(ALCAM Antibody) at dilution 1/15, on the right is treated with synthetic peptide. (Original magnification: ×200)
-
The image on the left is immunohistochemistry of paraffin-embedded Human gastric cancer tissue using CSB-PA104246(ALCAM Antibody) at dilution 1/15, on the right is treated with synthetic peptide. (Original magnification: ×200)
-
-
其他:
產品詳情
-
Uniprot No.:
-
基因名:
-
別名:Activated leukocyte cell adhesion molecule antibody; ALCAM antibody; ALCAM protein antibody; CD 166 antibody; CD166 antibody; CD166 antigen antibody; CD166_HUMAN antibody; FLJ3851 antibody; FLJ38514 antibody; MEMD antibody; MGC71733 antibody
-
宿主:Rabbit
-
反應種屬:Human,Mouse,Rat
-
免疫原:Synthetic peptide of Human ALCAM
-
免疫原種屬:Homo sapiens (Human)
-
標記方式:Non-conjugated
-
抗體亞型:IgG
-
純化方式:Antigen affinity purification
-
濃度:It differs from different batches. Please contact us to confirm it.
-
保存緩沖液:-20°C, pH7.4 PBS, 0.05% NaN3, 40% Glycerol
-
產品提供形式:Liquid
-
應用范圍:ELISA,IHC
-
推薦稀釋比:
Application Recommended Dilution ELISA 1:1000-1:2000 IHC 1:15-1:50 -
Protocols:
-
儲存條件:Upon receipt, store at -20°C or -80°C. Avoid repeated freeze.
-
貨期:Basically, we can dispatch the products out in 1-3 working days after receiving your orders. Delivery time maybe differs from different purchasing way or location, please kindly consult your local distributors for specific delivery time.
-
用途:For Research Use Only. Not for use in diagnostic or therapeutic procedures.
相關產品
靶點詳情
-
功能:Cell adhesion molecule that mediates both heterotypic cell-cell contacts via its interaction with CD6, as well as homotypic cell-cell contacts. Promotes T-cell activation and proliferation via its interactions with CD6. Contributes to the formation and maturation of the immunological synapse via its interactions with CD6. Mediates homotypic interactions with cells that express ALCAM. Required for normal hematopoietic stem cell engraftment in the bone marrow. Mediates attachment of dendritic cells onto endothelial cells via homotypic interaction. Inhibits endothelial cell migration and promotes endothelial tube formation via homotypic interactions. Required for normal organization of the lymph vessel network. Required for normal hematopoietic stem cell engraftment in the bone marrow. Plays a role in hematopoiesis; required for normal numbers of hematopoietic stem cells in bone marrow. Promotes in vitro osteoblast proliferation and differentiation. Promotes neurite extension, axon growth and axon guidance; axons grow preferentially on surfaces that contain ALCAM. Mediates outgrowth and pathfinding for retinal ganglion cell axons.; Inhibits activities of membrane-bound isoforms by competing for the same interaction partners. Inhibits cell attachment via homotypic interactions. Promotes endothelial cell migration. Inhibits endothelial cell tube formation.
-
基因功能參考文獻:
- multivariate Cox hazards regression analysis identified ALCAM and PD-L1 (both P < 0.01) as potential independent risk factors for primary diffuse pleural mesotheliomas PMID: 28811252
- Activated leukocyte cell adhesion molecule (ALCAM) has been implicated in tumorigenesis. PMID: 29315254
- this study establishes for the first time that CD166 is the ligand of ILT3. Blockade of CD166 by ILT3.Fc inhibited progression of human tumor cell lines in NOD.Cg-Prkdc Il-2rg/SzJ mice, suggesting its potential immunotherapeutic value. PMID: 29263213
- These data indicate that cardiac surgery influences the expression of CD162, CD166 and CD195 and that the intensity of the immune system response, displayed as the change in the CD162, CD166, CD195 expression, varies, depending on the surgical technique used. PMID: 27625334
- These findings indicate that high ALCAM expression is associated with poor prognosis and advanced clinicopathological characteristics in CRC patients. PMID: 28537909
- ALCAM is a potential mediator in the late complications of diabetes in the kidney. PMID: 28325697
- we show that although the histological detection of ALCAM within the tumor tissue correlates strongly with tumor stage in BCa (Figure (Figure2),2), it does not appear to be prognostic of overall survival. In contrast, urine ALCAM correlates with tumor stage and is a significant independent predictor of 3-year overall survival for patients after cystectomy. PMID: 27894096
- Our data indicate that Gal-8 interacts with ALCAM at the surface of breast cancer cells through glycosylation-dependent mechanisms. A novel heterophilic interaction between ALCAM and Gal-8 is demonstrated here, suggesting its physiologic relevance in the biology of breast cancer cells PMID: 27130882
- CD166 functions as a risk factor for cancers, and the alterations of its different functional isoforms were observed to correlate with specific or interplayed clinical outcomes. PMID: 27398729
- The results highlight the potential of ALCAM as a recurrent biomarker in early-stage endometrioid endometrial cancer and point to ALCAM as an important molecule in endometrial cancer dissemination by regulating cell migration, invasion, and metastasis. PMID: 27873306
- MiR-148a and miR-152 can sensitize tamoxifen-resistant MCF-7 breast cancer cells to tamoxifen via downregulating ALCAM. PMID: 28063929
- CHIP directly regulates the stability of CD166 protein through the ubiquitin proteasome system. PMID: 28279658
- ALCAM is overexpressed on the surface of Human T-lymphotropic virus type 1-infected lymphocytes, both in chronically infected cell lines and in primary infected CD4(+) T lymphocytes. PMID: 27252538
- ALCAM is upregulated in pancreatic stellate cells of pancreatic cancer tissues, suggesting a potential role of ALCAM in regulating pancreatic cancer cell-pancreatic stellate cells interactions. PMID: 27573419
- PRMT1 is overexpressed in human melanoma, and may regulate tumor growth and metastasis via targeting ALCAM. PMID: 27175582
- SFMSCs increased through upregulation of the activated lymphocyte cell adhesion molecule (ALCAM) and N-cadherin by microRNA-192 and -218 downregulation, similar to BMMSCs and ADMSCs. PMID: 28039611
- Analysis of KRAS mutation combined with immunohistochemical expression of CD44 and CD166 identified subgroups of patients with colon adenocarcinoma at higher risk of lymph node involvement by the tumor and development of liver and lung metastasis. PMID: 27062566
- Weak ALCAM expression was significantly correlated with established markers for poor prognosis, as well as shorter RFS and OS. ALCAM might be considered as a prognostic marker for infantile neuroblastoma PMID: 27466504
- CD166 antigen is specifically expressed on corneal endothelial cells. PMID: 26902886
- Prognostic Significance of CD44v6, CD133, CD166, and ALDH1 Expression in Small Intestinal Adenocarcinoma. PMID: 25710579
- The binding sites on CD6 and CD166 have been characterized to show that a SNP in CD6 causes glycosylation that hinders the CD6/CD166 interaction. PMID: 26146185
- a model that CD166 regulates MCAM through a signaling flow from activation of PI3K/AKT and c-Raf/MEK/ERK signaling to the inhibition of potential MCAM ubiquitin E3 ligases, betaTrCP and Smurf1 PMID: 26004137
- High ALCAM expression in melanoma cells of the primary tumor may indicate a more invasive phenotype. Low expression of ALCAM in regional lymph node metastases is a feature associated with unfavorable prognosis in patients with cutaneous melanoma. PMID: 26134500
- High ALCAM expression is associated with Invasive Cholangiocarcinoma. PMID: 25987048
- The Serum CD166 is a novel diagnostic tumor marker for hepatocellular carcinoma (HCC). PMID: 25562819
- Overexpression of activated leukocute cell adhesion molecule in gastric cancer is associated with advanced stages and poor prognosis and miR-9 deregulation PMID: 25395097
- Differentially expressed/regulated cancer-related genes upon miR-125b expression along with the significant increase of ALCAM PMID: 25539763
- Low expression of ALCAM at sites of cell-cell contact in primary breast cancer tumors regardless of differentiation, size and lymph node involvement may contribute to the more aggressive phenotype of breast cancer among African-American women. PMID: 25255861
- an overexpression of CD166 was detected in the benign and malignant salivary gland tumors and its expression in the malignant tumor was associated with the aggressive behavior and tumor progression. PMID: 25472586
- ALCAM is generally expressed in normal and cancerous breast epithelium and that a marked reduction of ALCAM expression characterizes a subset of breast cancer patients with adverse tumor characteristics and unfavorable clinical outcome. PMID: 25270339
- Authors propose a framework for how ALCAMs contribute to DC-T-cell adhesion, stabilize DC-T-cell contacts and form a mechanical link between CD6 and the actin cortex to strengthen cell adhesion at the immunological synapse. PMID: 24496453
- CD14(+)CD16(+) monocytes selectively transmigrated across our BBB model as a result of their increased JAM-A and ALCAM expression. PMID: 25420915
- miR126-5p is a functional, endothelial-enriched microRNA that participates in the control of leucocyte trafficking by regulating the expression of ALCAM and SetD5. PMID: 24562769
- Migration of CD166 positive progenitor cells to sites of cartilage damage may be directed by regulation of DCC/CREB signaling. PMID: 24966904
- The expression of CD166 using immunohistochemistry in a large cohort of non-small cell lung cancer patients , was evaluated. PMID: 24501004
- These show high p21 and CD166 expression at the pretreatment biopsy were associated with tumor regression and poor prognosis in patients treated with 5-FU based chemoradiotherapy PMID: 24708484
- High ALCAM expression is associated with brain metastasis. PMID: 24311639
- An antibody drug conjugate was generated recognizing the CD166 antigen which was found to be strongly up-regulated in all AML cell lines and AML blasts of some patients PMID: 24487095
- CD166 affected-CD44 expression is dependent of transcription via blocking NF-kappaB pathway. On the contrary, CD44 promoted up-regulation of CD166 mRNA and protein. PMID: 25094049
- By directly targeting the Rho GDP dissociation inhibitor alpha (RhoGDI1) and activated leukocyte cell adhesion molecule (ALCAM). PMID: 24710410
- ALCAM stably interacts with actin by binding to syntenin-1 and ezrin. PMID: 24662291
- this work summarizes a novel link between CD166 and YAP, explores the interplay among related important signaling pathways, and may lead to more effective therapeutic strategies for liver cancer. PMID: 24482231
- Patients whose head and neck squamous cell carcinoma tumors expressed high levels of CD166 had a significantly poorer clinical outcome than those whose tumors expressed low levels of CD166. PMID: 23903875
- ALCAM expression and shedding is elevated in response to TGF-beta signaling. PMID: 24385212
- The entry of HIV infected and uninfected CD14(+)CD16(+) monocytes into the brain was facilitated by significantly increased surface JAM-A, ALCAM, CD99, and PECAM-1, as compared to CD14(+) cells that are CD16 negative. PMID: 23922698
- Data indicate that arylsulfonamide inhibited ADAM-17 with selectivity, and maintained inhibitory properties on sALCAM shedding. PMID: 24044434
- CD166 expression indicate advanced tumor load category and node-positive status in colorectal cancer specifically. [Meta-analysis] PMID: 23940674
- Loss of E-cadherin and beta-catenin with cytoplasmic ALCAM accumulation may play pivotal role in oral cancer development and progression. PMID: 23840677
- ALCAM can be taken forward for analysis in sera of patients with thyroid carcinoma to determine its applicability as a minimally invasive serum biomarker for TC aggressiveness and patient disease-free survival. PMID: 23148625
- retention of intact ALCAM was associated with improved survival PMID: 23539446
顯示更多
收起更多
-
亞細胞定位:Cell membrane; Single-pass type I membrane protein. Cell projection, axon. Cell projection, dendrite.; [Isoform 3]: Secreted.
-
組織特異性:Detected on hematopoietic stem cells derived from umbilical cord blood. Detected on lymph vessel endothelial cells, skin and tonsil. Detected on peripheral blood monocytes. Detected on monocyte-derived dendritic cells (at protein level). Detected at low l
-
數據庫鏈接:
Most popular with customers
-
-
YWHAB Recombinant Monoclonal Antibody
Applications: ELISA, WB, IHC, IF, FC
Species Reactivity: Human, Mouse, Rat
-
Phospho-YAP1 (S127) Recombinant Monoclonal Antibody
Applications: ELISA, WB, IHC
Species Reactivity: Human
-
-
-
-
-